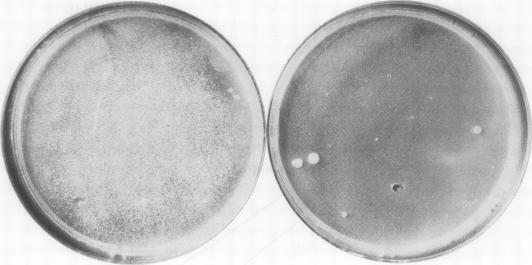
https://cdn.ncbi.nlm.nih.gov/pmc/blobs/71f7/476368/dbb6a4f091ed/jclinpath00161-0064-a.jpg

隐球菌性脑膜炎并发系统性红斑狼疮:两名接受氟胞嘧啶和两性霉素B治疗的患者
Cryptococcal meningitis complicating systemic lupus erythematosus: two patients treated with flucytosine and amphotericin B.
作者信息
Speller D C, Fakunle F, Cairns S A, Stephens M
出版信息
J Clin Pathol. 1977 Mar;30(3):254-61. doi: 10.1136/jcp.30.3.254.
Two fatal cases of cryptococcal meningitis complicating adrenocorticosteroid-treated systemic lupus erythermatosus are reported. In one patient who was treated with flucytosine alone, after an initial period of improvement cryptococci resistant to flucytosine were isolated, and subsequent amphotericine B treatment silated, and subsequent amphotericin B treatment did not alter the progress of the disease. In the second patient, who received both drugs concurrently, resistant cryptococci did not appear and the patient recovered sufficiently to return home. Flucytosine-resistant mutants could be demonstrated in vitro in the original cryptococcal isolated from both patients. The use of flucytosine and amphotericin B in combination is discussed.
报告了两例并发肾上腺皮质类固醇治疗的系统性红斑狼疮的新型隐球菌性脑膜炎致死病例。其中一名患者仅接受氟胞嘧啶治疗,在最初病情改善一段时间后,分离出对氟胞嘧啶耐药的新型隐球菌,随后使用两性霉素B治疗无效,疾病仍继续进展。第二名患者同时接受了两种药物治疗,未出现耐药的新型隐球菌,患者恢复良好并出院。在两名患者最初分离出的新型隐球菌中均能在体外证实存在氟胞嘧啶耐药突变体。本文讨论了氟胞嘧啶与两性霉素B联合使用的情况。